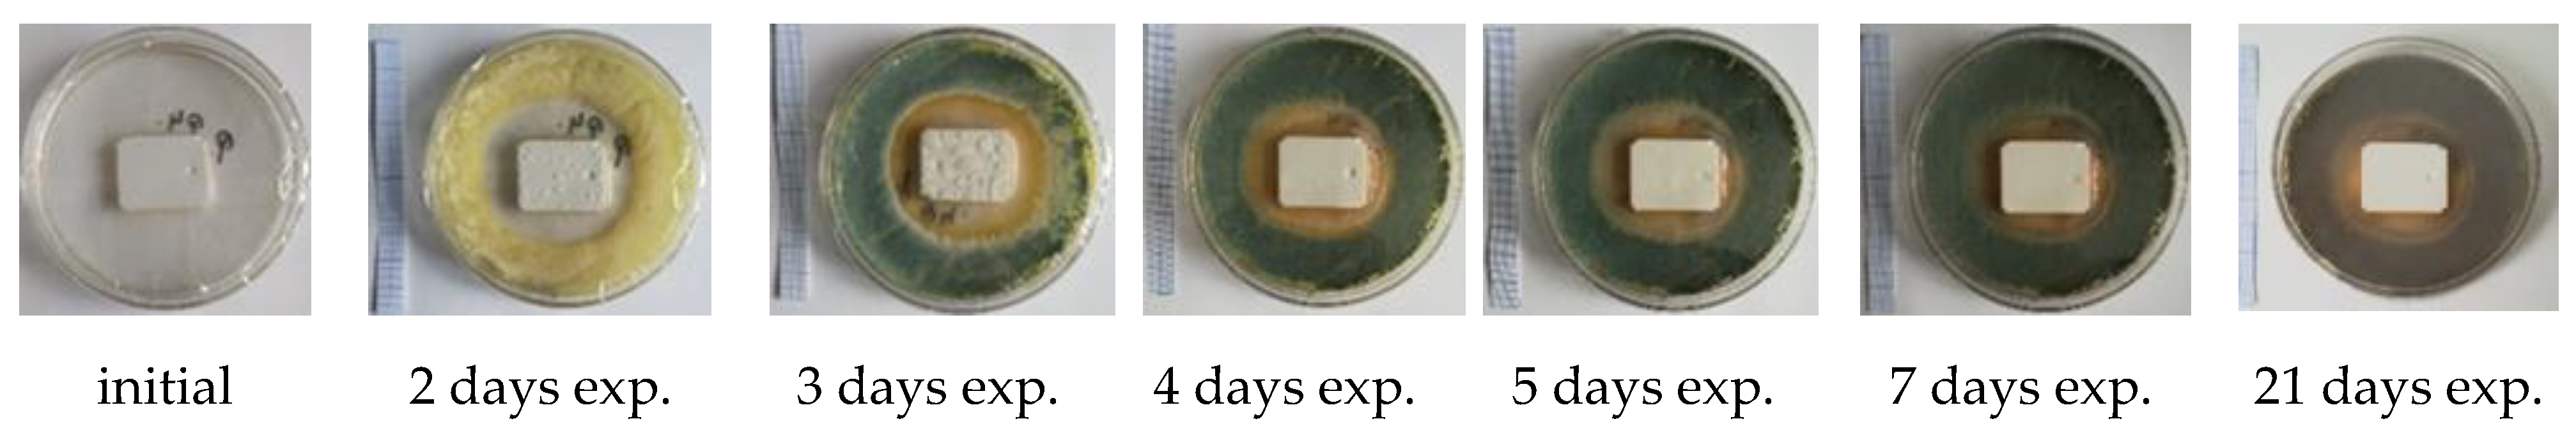
Materials 14 04442 g004 550

Influence of TiO2 Nanoparticles on the Resistance of Cementitious Composite Materials to the Action of Fungal Species
Abstract
:1. Introduction
2. Materials and Methods
2.1. Cementitious Composites Based on White Portland Cement with Nano-TiO2 Addition
2.2. Exposure of Cementitious Composite Samples Based on White Portland Cement with Nano-TiO2 Addition to an Environment Contaminated with Mold Spores
2.3. Analysis of the Experimental Results
- The percentage value, relative to the control sample, which represents the larger the diameter of the inhibition halo compared to the control’s inhibition diameter, (CPCM) calculated according to Equation (1):
- Reduction in the diameter of the inhibition halo over time (RDT) calculated according to Equation (2):where: —the diameter of the sample inhibition halo with % TiO2 at 2, respective 3 days exposure in contaminated environment; —the diameter of the inhibition halo of the control sample, with 0% TiO2, at 2, respectively 3 days exposure in contaminated environment; —sample inhibition halo diameter with % TiO2 at 2 days exposure in contaminated environment; —sample inhibition halo diameter with % TiO2 at i > 2 days exposure in contaminated environment.
2.4. Statistical Analysis
3. Results and Discussions
3.1. Assessment of the Ability to Inhibit Mold Development
- In case of exposure to an environment contaminated with A. niger spores in the control sample (0% TiO2) and in samples with 1% TiO2 and 2% TiO2, respectively, the diameter of the inhibition halo (D) decreases, completely disappearing after 5 days of exposure. The extinction of the inhibition halo was also observed on P8 sample (6% TiO2) after 6 days of exposure in the contaminated environment. In the case of samples containing 3.6%; 4%; 5% TiO2 in the cementitious matrix, the inhibition halo is maintained throughout the evaluation (28 days) in the case of contamination with A. niger spores (Figure 2a).
- In the control sample (0% TiO2), the diameter of the inhibition halo (D) decreases, completely disappearing after 3 days of exposure, in case of exposure to environment contaminated with P. notatum spores (Figure 3a).
- Compared to the control sample (0% TiO2), the diameters of the inhibition halo (D) recorded for all nano-TiO2-containing cementitious samples are significantly higher, regardless of the duration of exposure in the contaminated environment, indicating good biocidal activity in both mold cases. Relative to the diameter of the control inhibition halo, it is observed that the diameters of the inhibition halo of all samples containing nano-TiO2 are greater by 28–38% at 2 days and by 40–50% at 3 days of exposure in the environment contaminated with P. notatum spores and by 18% at 2 days and by 15% at 3 days of exposure in the environment contaminated for cementitious samples containing 3–6% nano-TiO2, in the case of an environment contaminated with A. niger spores (Figure 2b and Figure 3b). After 3 days of exposure, these assessments were no longer performed as the control samples for both P. notatum and A. niger contamination lost the inhibition halo. However, the subsequent behavior indicates that the biocidal efficiency is not directly proportional to the concentration of nanoparticles and, as a result of the behavior over time, it was assessed that a percentage greater than 5% nano–TiO2 in the cementitious matrix is not beneficial, neither economically nor in terms of efficiency. This finding could also be supported by some aspects reported in the literature. On one hand, there are reports showing the difficulty of homogeneous dispersion of nano-TiO2 in the cementitious matrix for cases where the amount of nanoparticles introduced is greater, they tend to agglomerate locally and the cementitious composite becomes inhomogeneous in terms of self–cleaning capacity [17,35,59]. On the other hand, by carrying out a parallel with studies on biocidal evolution in general, which indicate that in the case of too high a concentration of biocidal substance, the cell is no longer affected, and it is necessary in most cases to identify the optimal concentration of biocidal substance to obtain a biocidal effect [31,84,85], there is also in the case of these cementitious composites the possibility of too much activity, to which the cells no longer react. By correlating with some references reported in the literature, we can advance the hypothesis that fungi have the ability to bind TiO2 particles and fix them in the mycelium. Under conditions of too high concentration of nano-particles, the reaction of the fungi will be of concentration-induced resistance and the performance is no longer achieved [84,85].
- With regard to the evolution over time of the inhibition halo, their diameter decreases for all tested specimens, reducing, compared to the values recorded after exposure 2 days in a contaminated environment, by 2–5% after 3 days, 10–17% after 4 days, up to 27–33% after 28 days exposure in environment contaminated with P. notatum spores, highlighting the 2% nano–TiO2 composite sample with the smallest decrease halo of inhibition over time (Figure 3c). In case of contamination with A. niger spores, the reduction in inhibition halos over time (Figure 2c), evolves according to the duration of exposure and the content of nano–TiO2 in the cementitious matrix: samples at which this reduction is total after 5 days (P2, P3) or after 6 days (P4, P8), highlighting the composite samples with 3,6–5% nano–TiO2 showing the maintenance of the inhibition halo throughout the evaluation (28 days);
- In the visual analysis, with the naked eye, under the incidence of natural light, on the surface of none of the samples of cementitious material tested there were no traces of mold development, in case of contamination with spores of P. notatum, and isolated points with signs of initiation of mold growth after maintenance at least 7 days in an environment contaminated with A. niger;
- Microscopic analysis of the surface of the samples, the inhibition halo, the medial areas and the areas removed from the composite sample within the entire test system (Petri dish with PDA growth medium and cementitious composite sample), revealed the presence of three major areas of contamination and growth of the biological material (Figure 4, Figure 5, Figure 6 and Figure 7):
- ◦
- The inhibition zone extending circularly around the cementitious composite sample to a maximum distance equal to the diameter of the inhibition halo (D). In this area, the degree of contamination corresponds to the characterization “sterile” or maximum “1–10 colonies of microorganisms”
- ◦
- The transition zone in which the biological charge, the density of mold colonies, increases as the distance from the edge of the cementitious composite specimen increases
- ◦
- The area of intense growth, in the extremity of the analyzed system, in which the biological load, the density of mold colonies, is so great that independent units can no longer be identified, all being confluent with each other.
3.2. Assessment of the Influence of the Shape and Size of the Specimen on the Resistance to Mold Development
3.3. Data Analysis
4. Conclusions
- All test systems showed three major zones of contamination and growth of biological material: the zone of inhibition halo (in the immediate vicinity of the cementitious sample, with a biological load of maximum 1–10 colonies of microorganisms); the transition zone in which the biological load, the density of mold colonies, increases as the distance from the edge of the cementitious composite specimen increases and the zone of intense growth (at the extremity of the test system, where the biological load is so large that independent colony units can no longer be identified, all of which are confluent with each other).
- No traces of P. notatum mold development were observed on the surface of any of the tested cementitious material samples. The surface of the cementitious composites exposed in an environment contaminated with A. niger showed isolated spots with signs of mold growth initiation, after conditioning for at least 7 days of testing.
- As the duration of exposure of the cementitious samples in the contaminated environment increases, depending on the content of nano–TiO2, the dimensions of the inhibition halo change to reduce them. Thus, in the case of A. niger it disappears completely after 5 days of testing for the control sample (P1) and for the mixtures P2 and P3 (with 1% TiO2 and 2% TiO2, respectively) and after 6 days of testing for the sample P8 (6% TiO2). For P3, P4 and P5 composites (3.6%; 4%; 5% TiO2) the inhibition halo is maintained throughout the testing period (28 days), showing dimensional reductions in the first 3–4 days, after which a relative stabilization is observed. In case of exposure to P. notatum spores contaminated environment the control sample P1 (0% TiO2) loses the inhibition halo after 3 days of testing but all TiO2-containing cementitious composites (P2–P8) the inhibition halo is maintained throughout the test.
- The mix–design of cementitious composites mixtures included two extreme variants of nano–TiO2 content, respectively P1 (0% nano–TiO2) and P8 (6% nano–TiO2) following several hypotheses:
- ◦
- Thus, (I) the hypothesis of the biocidal effect of photoactivation of nanoparticles in the cementitious matrix was confirmed based on the comparison of the characteristics of inhibition haloes compared to the control sample, P1 (0% nano-TiO2).
- ◦
- The hypothesis of increasing the proportional and continuous biocidal effect, with the increase in the content of nano–TiO2 in the cementitious matrix (II) was disproved by identifying the maximum functionality threshold, respectively, P7 (5% nano–TiO2), and by the less efficient behavior of the composite P8 (6% nano–TiO2). The behavior of this excess nanoparticle composite can be accepted on the basis of two hypotheses extracted in accordance with the specifications of the literature and which will be developed in future studies: (1) the difficulty of homogeneous dispersion of a large amount of nanoparticles in the cementitious matrix which results in the inhomogeneity of the composite with the existence of agglomeration areas of nanoparticles and areas with insufficient nano–TiO2 content and (2) the possibility that, some known biocidal treatment solutions, too high a concentration causes the cell to become insensitive. Analyzing CPCM and RTD in the case of P. notatum, a slight increase in this indicator for the analyzed mixtures was observed when using 6% nano-TiO2 addition, compared to 5%. However, it was assessed that this increase in the efficiency of the biocide effect is not necessarily sufficiently motivating for an increase in the concentration of nano–TiO2 to 6%, which also attracts an increase in production costs. Moreover, it can be said that for different species of mold, the effectiveness of the addition of TiO2 nanoparticles reacts differently and detailed research is needed for each individual case.
- ◦
- In addition, the hypothesis that the introduction of some amount of nano–TiO2 into the cementitious matrix automatically induces a capacity for resistance to mold growth, regardless of its species Type (III) is disproved by two observations as follows: (1) an insufficient amount of nanoparticles does not ensure the maintenance of the inhibition halo (see behavior of mixtures P2 (1% TiO2), P3 (2% TiO2) exposed in a contaminated environment with A. niger) and therefore does not ensure the durability of the biocidal effect and (2) the resistance to mold development differs according to its species, as demonstrated by comparing the behavior of composites with the same content of nano-TiO2 exposed in each of the two contaminating media.
- The differentiation of the shape/dimensions of the tested samples contributed to the evaluation of the acceptability of the hypothesis (IV) that considers that the geometric aspects of the tested cementitious composite sample are defining for the quantitative and qualitative indicators of evaluation of the biocidal effect. In this sense, it can be said that the geometric aspects influence to some extent the quantitative indicators, but, certainly, cannot influence qualitatively the proof of the effect of inhibition of mold growth, a statement supported by the circular shape of the inhibition halo (the most obvious qualitative initiator) even in the case of cementitious composite samples with rectangular shape. However, in order to facilitate and increase the accuracy of measurements and quantitative evaluation, a disc shape of the test specimens was considered desirable.
- Statistical analysis of quantitative performance evaluation indicators (inhibition halo dimensions) was a useful tool for supporting decisions to confirm or refute the previously mentioned hypotheses. The results obtained experimentally and analyzed statistically open a new direction in the continuation of experimental researches aimed at maintaining the ability to inhibit the development of fungi even after the action of the aging process, the small concentrations having the chance of not inducing resistance to biocide action over time.
Author Contributions
Funding
Institutional Review Board Statement
Informed Consent Statement
Data Availability Statement
Acknowledgments
Conflicts of Interest
References
- Haleem Khan, A.A.; Mohan Karuppayil, S. Fungal pollution of indoor environments and its management. Saudi. J. Biol. Sci. 2012, 19, 405–426. [Google Scholar] [CrossRef] [Green Version]
- Nergis, D.D.B.; Vizureanu, P.; Ardelean, I.; Sandu, A.V.; Corbu, O.; Matei, E. Revealing the Influence of Microparticles on Geopolymers’ Synthesis and Porosity. Materials 2020, 13, 3211. [Google Scholar] [CrossRef]
- Ebbehoj, N.E.; Hansen, M.O.; Sigsgaard, T.; Larsen, L. Building-related symptoms and molds: A two-step intervention study. Indoor Air 2002, 12, 273–277. [Google Scholar] [CrossRef]
- Zeliger, H.I. Toxic effects of chemical mixtures. Arch. Environ. Health 2003, 58, 23–29. [Google Scholar] [CrossRef]
- Peuhkuri, R.; Viitanen, H.; Ojanen, T.; Vinha, J.; Lähdesmäki, K. Resistance against mould of building materials under constant conditions. In Proceedings of the Finnish Building Physics Symposium 2009: The Newest Research Results and Good Practical Solutions, Tampere, Finland, 27–29 October 2009. [Google Scholar]
- Hope, J. A Review of the Mechanism of Injury and Treatment Approaches for Illness Resulting from Exposure to Water-Damaged Buildings, Mold, and Mycotoxins. Sci. World J. 2013, 2013, 767482. [Google Scholar] [CrossRef] [PubMed] [Green Version]
- Żukiewicz-Sobczak, W.; Sobczak, P.; Krasowska, E.; Zwoliński, J.; Chmielewska-Badora, J.; Galińska, E.M. Allergenic potential of moulds isolated from buildings. Ann. Agric. Environ. Med. 2013, 20, 500–503. [Google Scholar]
- Agag, B.I. Mycotoxins in foods and feeds. Ass. Univ. Bull. Environ. Res. 2004, 7, 3554731. [Google Scholar]
- Rosen, E.; Heseltine, J. WHO Guidelines for Indoor Air quality: Dampness and Mould; WHO Regional Office for Europe: Copenhagen, Denmark, 2009. [Google Scholar]
- Fisk, W.J.; Lei-Gomez, Q.; Mendell, M.J. Meta-analyses of the associations of respiratory health effects with dampness and mold in homes. Indoor Air 2007, 17, 284–296. [Google Scholar] [CrossRef] [PubMed]
- Mudarri, D.; Fisk, W.J. Public health and economic impact of dampness and mold. Indoor Air 2007, 17, 226–235. [Google Scholar] [CrossRef] [Green Version]
- Jaakkola, J.J.K.; Hwang, B.F.; Jaakkola, N. Home dampness and molds, parental atopy, and asthma in childhood: A sixyear population-based cohort study. Environ. Health Perspect. 2005, 113, 357–361. [Google Scholar] [CrossRef]
- Hope, J.H.; Hope, B.E. A review of the diagnosis and treatment of Ochratoxin A inhalational exposure associated with human illness and kidney disease including focal segmental glomerulosclerosis. J. Environ. Res. Public Health 2012, 2012, 835059. [Google Scholar] [CrossRef]
- Karvala, K.; Toskala, E.; Luukkonen, R.; Lappalainen, S.; Uitti, J.; Nordman, H. New-onset adult asthma in relation to damp and moldy workplaces. Int. Arch. Occup. Environ. Health 2010, 83, 855–865. [Google Scholar] [CrossRef]
- Doi, K.; Uetsuka, K. Mechanisms of mycotoxin-induced neurotoxicity through oxidative stressassociated pathways. Int. J. Mol. Sci. 2011, 12, 5213–5237. [Google Scholar] [CrossRef] [Green Version]
- Haverinen-Shaughnessy, U. Prevalence of dampness and mold in European housing stock. J. Expo. Sci. Environ. Epidemiol. 2012, 22, 461–467. [Google Scholar] [CrossRef] [Green Version]
- Graziani, L.; Quagliarini, E.; Bondioli, F.; D’Orazio, M. Durability of self-cleaning TiO2 coatings on fired clay brick façades: Effects of UV exposure and wet & dry cycles. Build. Environ. 2014, 71, 193–203. [Google Scholar]
- Cucek, L.; Klemes, J.J.; Kravanja, Z. A review of footprint analysis tools for monitoring impacts on sustainability. J. Clean. Prod. 2012, 34, 9–20. [Google Scholar] [CrossRef]
- Chiarini, A. Strategies for Developing an Environmentally Sustainable Supply Chain: Differences between Manufacturing and Service Sectors. Bus. Strat. Env. 2014, 23, 493–504. [Google Scholar] [CrossRef]
- Andersen, B.; Frisvad, J.C.; Søndergaard, I.; Rasmussen, S.; Larsen, L.S. Associations between Fungal Species and Water-Damaged Building Materials. Appl. Environ. Microbiol. 2011, 77, 4180–4188. [Google Scholar] [CrossRef] [Green Version]
- Baxter, D.M.; Perkins, J.L.; McGhee, C.R.; Seltzer, J.M. A Regional Comparison of Mold Spore Concentrations Outdoors and Inside “Clean” and “Mold Contaminated” Southern California Buildings. J. Occup. Environ. Hyg. 2005, 2, 8–18. [Google Scholar] [CrossRef] [PubMed]
- Chen, H.; Deng, S.; Bruner, H.; Garcia, J. Roots of Mold Problems and Humidity Control Measures in Institutional Buildings with Pre-Existing Mold Condition; Texas A&M University: Richardson, TX, USA, 2004. [Google Scholar]
- Wang, L.; Hu, C.; Shao, L. The antimicrobial activity of nanoparticles: Present situation and prospects for the future. Int. J. Nanomed. 2017, 12, 1227–1249. [Google Scholar] [CrossRef] [PubMed] [Green Version]
- Kühn, K.P.; Chaberny, I.F.; Massholder, K.; Stickler, M.; Benz, V.W.; Sonntag, H.G.; Erdinger, L. Disinfection of surfaces by photocatalytic oxidation with titanium dioxide and UVA light. Chemosphere 2003, 53, 71–77. [Google Scholar] [CrossRef]
- Machida, M.; Norimoto, K.; Kimura, T. Antibacterial Activity of Photocatalytic Titanium Dioxide Thin Films with Photodeposited Silver on the Surface of Sanitary Ware. J. Am. Ceram. Soc. 2005, 88, 95–100. [Google Scholar] [CrossRef]
- Watts, R.J.; Kong, S.; Orr, M.P.; Miller, G.C.; Henry, B.E. Photocatalytic inactivation of coliform bacteria and viruses in secondary wastewater effluent. Water Res. 1995, 29, 95–100. [Google Scholar] [CrossRef]
- Vohra, A.; Goswami, D.Y.; Deshpande, D.A.; Block, S.S. Enhanced photocatalytic inactivation of bacterial spores on surfaces in air. J. Ind. Microbiol. Biotechnol. 2005, 32, 364–370. [Google Scholar] [CrossRef]
- Fujishima, A.; Rao, T.N.; Tryk, D.A. Titanium dioxide photocatalysis. J. Photochem. Photobiol. C 2000, 1, 1–21. [Google Scholar] [CrossRef]
- Irie, H.; Hashimoto, K. Photocatalytic Active Surfaces and Photo-Induced High Hydrophilicity/High Hydrophobicity. Hdb. Env. Chem. 2005, 2, 425–450. [Google Scholar]
- Chen, J.; Poon, C.-S. Photocatalytic construction and building materials: From fundamentals to applications. Build. Environ. 2009, 44, 1899–1906. [Google Scholar] [CrossRef]
- Kashyout, A.B.; Soliman, M.; El-Haleem, D.A. Disinfection of bacterial suspensions by photocatalytic oxidation using TiO2 nanoparticles under ultraviolet illumination. AEJ-Alex. Eng. J. 2006, 45, 367–371. [Google Scholar]
- Fujishima, A.; Zhang, X. Titanium dioxide photocatalysis: Present situation and future approaches. CR Chim. 2006, 9, 750–760. [Google Scholar] [CrossRef]
- Guan, K. Relationship between photocatalytic activity, hydrophilicity and selfcleaning effect of TiO2/SiO2 films. Surf. Coat. Tech. 2005, 191, 155–160. [Google Scholar] [CrossRef]
- Lee, Y.C.; Hong, Y.P.; Lee, H.Y.; Kim, H.; Jung, Y.J.; Ko, K.H. Photocatalysis and hydrophilicity of doped TiO2 thin films. J. Colloid. Interf. Sci. 2003, 267, 127–131. [Google Scholar] [CrossRef]
- Graziani, L.; Quagliarini, E.; Osimani, A.; Aquilanti, L.; Clementi, F.; Yéprémian, C. Evaluation of inhibitory effect of TiO2 nanocoatings against microalgal growth on clay brick façades under weak UV exposure conditions. Build. Environ. 2013, 64, 38–45. [Google Scholar] [CrossRef]
- Li, C.; Chang, S.J.; Tai, M.Y. Surface chemistry and dispersion property of TiO2 nanoparticles. J. Am. Ceram. Soc. 2010, 93, 4008–4010. [Google Scholar] [CrossRef]
- Yu, J.; Low, J.; Wei, X. Enhanced photocatalytic CO2-reduction activity of anatase TiO2 by Co-exposed {001} and {101} facets. J. Am. Chem. Soc. 2014, 136, 8839–8842. [Google Scholar] [CrossRef]
- Wang, R.; Hashimoto, K.; Fujishima, A.; Chikuni, M.; Kojima, E.; Kitamura, A.; Shimohigoshi, M.; Watanabe, T. Photogeneration of highly amphiphilic TiO2 surfaces. Adv. Mater. 1998, 10, 135–138. [Google Scholar] [CrossRef]
- Wang, R.; Sakai, N.; Fujishima, A.; Watanabe, T.; Hashimoto, K. Studies of Surface Wettability Conversion on TiO2 Single-Crystal Surfaces. J. Phys. Chem. B. 1999, 103, 2188–2194. [Google Scholar] [CrossRef]
- Nosaka, A.Y.; Kojima, E.; Fujiwara, T.; Yagi, H.; Akutsu, H.; Nosaka, Y. Photoinduced Changes of Adsorbed Water on a TiO2 Photocatalytic Film As Studied by 1H NMR Spectroscopy. J. Phys. Chem. B. 2003, 107, 12042–12044. [Google Scholar] [CrossRef]
- Sakai, N.; Fujishima, A.; Watanabe, T.; Hashimoto, K. Enhancement of the Photoinduced Hydrophilic Conversion Rate of TiO2 Film Electrode Surfaces by Anodic Polarization. J. Phys. Chem. B. 2001, 105, 3023–3026. [Google Scholar] [CrossRef]
- Bianchi, C.L.; Gatto, S.; Nucci, S.; Cerrato, G.; Capucci, V. Self-cleaning measurements on tiles manufactured with microsized photoactive TiO2. Adv. Mater. Res. 2013, 2, 65–75. [Google Scholar] [CrossRef] [Green Version]
- Sikora, P.; Cendrowski, K.; Markowska-Szczupak, A.; Horszczaruk, E.; Mijowska, E. The effects of silica/titania nanocomposite on the mechanical and bactericidal properties of cement mortars. Constr. Build Mater. 2017, 150, 738–746. [Google Scholar] [CrossRef]
- Guo, M.-Z.; Maury-Ramirez, A.; Poon, C.S. Self-cleaning ability of titanium dioxide clear paint coated architectural mortar and its potential in field application. J. Clean. Prod. 2016, 112, 3583–3588. [Google Scholar] [CrossRef]
- Howard, A.; Foster, H.A.; Ditta, I.B.; Varghese, S.; Steele, A. Photocatalytic disinfection using titanium dioxide: Spectrum and mechanism of antimicrobial activity. Appl. Microbiol. Biotechnol. 2011, 90, 1847–1868. [Google Scholar]
- Akiba, N.; Hayakawa, I.; Keh, E.S.; Watanabe, A. Antifungal effects of a tissue conditioner coating agent with TiO2 photocatalyst. J. Med. Dent. Sci. 2005, 52, 223–227. [Google Scholar]
- Oksanen, J.; Blanchet, F.G.; Friendly, M.; Kindt, M.; Legendre, P.; McGlinn, D.; Minchin, P.R.; O’Hara, R.B.; Simpson, G.L.; Solymos, P.; et al. Community Ecology Package. R Package Version 2.5-7. 2020. Available online: https://CRAN.R-project.org/package=vegan (accessed on 17 February 2021).
- Cunningham, J.; Srijaranai, S. Isotope-effect evidence for hydroxyl radical involvement in alcohol photo-oxidation sensitized by TiO2 in aqueous suspension. J. Photochem. Photobiol. A Chem. 1998, 43, 329–335. [Google Scholar] [CrossRef]
- Brezová, V.; Stasko, A.; Lapcik, L., Jr. Electron paramagnetic resonance study of photogenerated radicals in titanium dioxide powder and its aqueous suspensions. J. Photochem. Photobiol. A Chem. 1991, 59, 59–115. [Google Scholar] [CrossRef]
- Kamat, P.V. Photochemistry on nonreactive and reactive (semiconductor) surfaces. Chem. Rev. 1993, 93, 267–300. [Google Scholar] [CrossRef]
- Courbon, H.; Formenti, M.; Pichat, P.J. Study of oxygen isotopic exchange over ultraviolet irradiated anatase samples and comparison with the photooxidation of isobutane into acetone. Phys. Chem. 1977, 81, 550–554. [Google Scholar] [CrossRef]
- Anpo, M.; Chiba, K.; Tomonari, M.; Coluccia, S.; Che, M.; Fox, M.A. Photocatalysis on Native and Platinum-Loaded TiO2 and ZnO Catalysts-Origin of Dierent Reactivities onWet and Dry Metal Oxides. Bull. Chem. Soc. Jpn. 1991, 64, 543–551. [Google Scholar] [CrossRef]
- Sun, L.; Bolton, J.R. Determination of the Quantum Yield for the Photochemical Generation of Hydroxyl Radicals in TiO2 Suspensions. J. Phys. Chem. 1996, 100, 4127–4134. [Google Scholar] [CrossRef]
- Grela, M.A.; Coronel, M.E.J.; Colussi, A.J. Quantitative Spin-Trapping Studies ofWeakly Illuminated Titanium Dioxide Sols. Implications for the Mechanism of Photocatalysis. J. Phys. Chem. 1996, 100, 16940–16946. [Google Scholar] [CrossRef]
- Jayapalan, A.R.; Lee, B.Y.; Fredrich, S.M.; Kurtis, K.E. Influence of Additions of Anatase TiO2 Nanoparticles on Early-Age Properties of Cement-Based Materials. Transp. Res. Rec. J. Transp. Res. Board 2010, 2141, 41–46. [Google Scholar] [CrossRef] [Green Version]
- Kurihara, R.; Maruyama, I. Influences of nano-TiO2 particles on alteration of microstructure of hardened cement. Annu. Proc. Concr. Eng. 2016, 38, 219–224. [Google Scholar]
- Mendes, T.M.; Hotza, D.; Repette, W.L. Nanoparticles in cement based materials: A review. Rev. Adv. Mater. Sci. 2015, 40, 89–96. [Google Scholar]
- Skorb, E.V.; Antonouskaya, L.I.; Belyasova, N.A.; Shchukin, D.G.; Mo¨hwald, H.; Sviridov, D.V. Antibacterial activity of thin-film photocatalysts based on metal-modified TiO2 and TiO2:In2O3 nanocomposite. App. Catal. B Environ. 2008, 84, 94–99. [Google Scholar] [CrossRef]
- Li, W.; Xiao, L.; Wang, X.; Ran, Y. A Review of Mechanical Properties and Durability of Nano-concrete. Adv. Eng. Res. 2017, 136, 5–8. [Google Scholar]
- Linkous, C.A.; Carter, G.J.; Locuson, D.V.; Ouellette, A.J.; Slattery, D.K.; Smith, L.A. Photocatalytic inhibition of algae growth using TiO2, WO3, and cocatalyst modifications. Environ. Sci. Technol. 2000, 34, 4754–4758. [Google Scholar] [CrossRef]
- Klich, M. Health effects of Aspergillus in food and air. Toxicol. Ind. Health 2009, 25, 657–667. [Google Scholar] [CrossRef]
- Hong, J.; Ma, H.; Otaki, M. Controlling algal growth in photodependent decolorant sludge by photocatalysis. J. Biosci. Bioeng. 2005, 6, 592–597. [Google Scholar] [CrossRef] [PubMed]
- Karvala, K.; Nordman, H.; Luukkonen, R. Occupational rhinitis in damp and moldy workplaces. Am. J. Rhinol. Allergy. 2008, 22, 457–462. [Google Scholar] [CrossRef] [PubMed]
- Renz, C. Lichtreaktionen der Oxyde des Titans, Cers und der Erdsauren. Helv. Chim. Acta 1921, 4, 961–968. [Google Scholar] [CrossRef] [Green Version]
- Matusunga, T. Sterilization with particulate photosemiconductor. J. Antibact. Antifung. Agents 1985, 13, 211–220. [Google Scholar]
- Matsunaga, T.; Tomoda, R.; Nakajima, T.; Wake, H. Photoelectrochemical sterilization of microbial cells by semiconductor powders. FEMS Microbiol. Lett. 1985, 29, 211–214. [Google Scholar] [CrossRef]
- Matsunaga, T.; Tomoda, R.; Nakajima, T.; Nakamura, N.; Komine, T. Continuous-sterilization system that uses photosemiconductor powders. Appl. Environ. Microbiol. 1988, 54, 1330–1333. [Google Scholar] [CrossRef] [PubMed] [Green Version]
- Giannantonio, D.J.; Kurth, J.C.; Kurtis, K.E.; Sobecky, P.A. Effects of concrete properties and nutrients on fungal colonization and fouling. Int. Biodeterior. Biodegrad. 2009, 63, 252–259. [Google Scholar] [CrossRef]
- Sökmen, M.; Candan, F.; Sümer, Z. Disinfection of E. coli by the Ag–TiO2/UV system: Lipidperoxidation. J. Photochem. Photobiol. A 2001, 143, 241–244. [Google Scholar] [CrossRef]
- Sökmen, M.; Degerli, S.; Aslan, A. Photocatalytic disinfection of Giardia intestinalis and Acanthamoeba castellani cysts in water. Exp. Parasitol. 2008, 119, 44–48. [Google Scholar] [CrossRef] [PubMed]
- Kikuchi, Y.; Sunada, K.; Iyoda, T.; Hashimoto, K.; Fujishima, A. Photocatalytic bactericidal effect of TiO2 thin films: Dynamic view of the active oxygen species responsible for the effect. J. Photochem. Photobiol. A 1997, 106, 51–56. [Google Scholar] [CrossRef]
- Sunada, K.; Watanabe, T.; Hashimoto, K. Studies on photokilling of bacteria on TiO2 thin film. J. Photochem. Photobiol. A 2003, 156, 227–233. [Google Scholar] [CrossRef]
- Ditta, I.B.; Steele, A.; Liptrot, C.; Tobin, J.; Tyler, H.; Yates, H.M.; Sheel, D.W.; Foster, H.A. Photocatalytic antimicrobial activity of thin surface films of TiO2, CuO and TiO2/CuO dual layers on Escherichia coli and bacteriophage T4. Appl. Microbiol. Biotechnol. 2008, 79, 127–133. [Google Scholar] [CrossRef] [PubMed] [Green Version]
- Brook, L.A.; Evans, P.; Foster, H.A.; Pemble, M.E.; Steele, A.; Sheel, D.W.; Yates, H.M. Highly bioactive silver and silver/titania composite films grown by chemical vapour deposition. J. Photochem. Photobiol. 2007, 187, 53–63. [Google Scholar] [CrossRef] [Green Version]
- Yates, H.M.; Brook, L.A.; Ditta, I.B.; Evans, P.; Foster, H.A.; Sheel, D.W.; Steele, A. Photo-induced self-cleaning and biocidal behaviour of titania and copper oxide multilayers. J. Photochem. Photobiol. A 2008, 195, 197–205. [Google Scholar] [CrossRef]
- Yates, H.M.; Brook, L.A.; Sheel, D.W.; Ditta, I.B.; Steele, A.; Foster, H.A. The growth of copper oxides on glass by flame assisted chemical vapour deposition. Thin Solid Film. 2008, 517, 517–521. [Google Scholar] [CrossRef]
- Burduhos Nergis, D.D.; Vizureanu, P.; Corbu, O. Synthesis and characteristics of local fly ash based geopolymers mixed with natural aggregates. Rev. Chim. 2019, 70, 1262–1267. [Google Scholar] [CrossRef]
- Yahya, Z.; Abdullah, M.M.A.B.; Ramli, N.M.; Burduhos-Nergis, D.D.; Abd Razak, R. Influence of Kaolin in Fly Ash Based Geopolymer Concrete: Destructive and Non-Destructive Testing. IOP Conf. Ser. Mater. Sci. Eng. 2018, 374, 012068. [Google Scholar] [CrossRef]
- RStudio Team. RStudio: Integrated Development Environment for R; RStudio PBC: Boston, MA, USA, 2021; Available online: http://www.rstudio.com/Version1.4.1106 (accessed on 21 March 2021).
- R Core Team. R: A Language and Environment for Statistical Computing; R Foundation for Statistical Computing: Vienna, Austria, 2021; Available online: https://www.R-project.org/ (accessed on 21 March 2021).
- Revelle, W. Psych: Procedures for Personality and Psychological Research; Northwestern University: Evanston, IL, USA, 2020; Available online: https://CRAN.R-project.org/package=psychVersion=2.0.12 (accessed on 21 March 2021).
- De Mendiburu, F. Agricolae: Statistical Procedures for Agricultural Research. R Package Version 1.3-3. 2020. Available online: https://CRAN.R-project.org/package=agricolae (accessed on 21 March 2021).
- Robinson, D.; Hayes, A.; Couch, S. Convert Statistical Objects into Tidy Tibbles. R Package Version 0.7.6. Available online: https://CRAN.R-project.org/package=broom (accessed on 21 March 2021).
- Firmino, H.C.; Nascimento, E.P.; Bonan, R.F.; Maciel, P.P.; Castellano, L.R.; Santana, L.N.; Neves, G.A.; Menezes, R.R. Antifungal activity of TiO2-CeO2 nanofibers against Candida fungi. Mater. Lett. 2021, 283, 128709. [Google Scholar] [CrossRef]
- Šebesta, M.; Nemček, L.; Urík, M.; Kolenčík, M.; Bujdoš, M.; Hagarová, I.; Matúš, P. Distribution of TiO2 nanoparticles in acidic and alkaline soil and their accumulation by Aspergillus niger. Agronomy 2020, 10, 1833. [Google Scholar] [CrossRef]

| Mixture | P1 | P2 | P3 | P4 | P5 | P6 | P7 | P8 |
|---|---|---|---|---|---|---|---|---|
| Amount of Nanoparticles Relative to The Amount of Cement (%) | 0 | 1 | 2 | 3 | 3.6 | 4 | 5 | 6 |
| CEM I 52.5R White Cement, HOLCIM ROMANIA (g) | 500 | 500 | 500 | 500 | 500 | 500 | 500 | 500 |
| Quantity of Water Relative to Quantity of Total Dry Mixture (water/(cement + nano–TiO2)) (g) | 0.45–0.50 | |||||||
| Conditioning | 24 h in Molds, 90% RH, 20 °C, without Light; Demolding. 27 Days of Total Immersion in Water, 20 °C, without Light; Until Photoactivation Followed by Testing, under Laboratory Conditions, without Light | |||||||
| 2 Days Exposure | 3 Days Exposure | 4 Days Exposure | 5 Days Exposure | 6 Days Exposure | 7 Days Exposure | 14 Days Exposure | 21 Days Exposure | 28 Days Exposure | |
|---|---|---|---|---|---|---|---|---|---|
| P1 | 34.98 ± 0.23 c | 34.89 ± 0.32 c | 23.25 ± 1.52 c | ||||||
| P2 | 37.51 ± 0.22 b | 37.44 ± 0.44 bc | 24.64 ± 0.39 bc | ||||||
| P3 | 35.04 ± 0.13 c | 34.92 ± 0.64 c | 25.99 ± 0.34 bc | ||||||
| P4 | 40.9 ± 0.37 a | 40.27 ± 1.06 ab | 31.86 ± 0.65 b | 19.25 ± 0.02 d | |||||
| P5 | 40.95 ± 0.13 a | 40.73 ± 0.78 a | 31.44 ± 0.62 a | 26.11 ± 0.74 bc | 24.69 ± 1.05 b | 23.81 ± 1.25 b | 23.79 ± 0.48 b | 23.79±1.03 a | 23.69 ± 1.04 a |
| P6 | 41.06 ± 0.26 a | 40.94 ± 0.46 a | 30.89 ± 0.32 a | 27.88 ± 0.59 b | 27.27 ± 1.56 ab | 27.02 ± 1.12 b | 26.78 ± 0.32 a | 26.12±0.29 a | 25.64 ± 0.38 a |
| P7 | 41.37 ± 0.12 a | 41.21 ± 0.81 a | 31.37 ± 0.25 a | 31.35 ± 0.78 a | 31.38 ± 1.02 a | 31.23 ± 0.58 a | 26.73 ± 0.72 a | 25.53±0.84 a | 25.22 ± 0.73 a |
| P8 | 40.52 ± 0.13 a | 40.22 ± 0.6 ab | 27.56 ± 0.46 a | 23.87 ± 0.76 c | |||||
| F. test | 165.35 | 15.78 | 25.41 | 49.35 | 7.45 | 13.20 | 10.32 | 2.37 | 1.78 |
| p val | 0.000 | 0.000 | 0.000 | 0.000 | 0.008 | 0.001 | 0.002 | 0.136 | 0.210 |
| 2 Days Exposure | 3 Days Exposure | 4 Days Exposure | 5 Days Exposure | 6 Days Exposure | 7 Days Exposure | 14 Days Exposure | 21 Days Exposure | 28 Days Exposure | |
|---|---|---|---|---|---|---|---|---|---|
| P1 | 40.83 ± 1.46 c | 36.1 ± 1.22 b | |||||||
| P2 | 52.89 ± 0.65 ab | 51.42 ± 0.87 a | 47.37 ± 1.41 ab | 45.79 ± 1.75 ab | 43.27 ± 1.42 a | 38.53 ± 1.93 a | 38.46 ± 0.3 b | 36.91 ± 0.79 a | 36.69 ± 0.83 a |
| P3 | 53.06 ± 1.44 ab | 52.8 ± 0.75 a | 46.82 ± 1.29 ab | 42.6 ± 0.63 bcd | 41.89 ± 0.62 ab | 40.23 ± 1.27 a | 40.16 ± 0.27 ab | 40.04 ± 1.02 a | 39.68 ± 0.97 a |
| P4 | 54.07 ± 0.57 ab | 52.76 ± 0.93 a | 44.7 ± 1.52 ab | 40.42 ± 1.16 cd | 39.58 ± 1 ab | 38.09 ± 0.9 a | 37.96 ± 0.88 b | 36.31 ± 1.18 a | 36.25 ± 1.05 a |
| P5 | 52.46 ± 0.78 b | 51.05 ± 0.7 a | 43.41 ± 0.96 b | 38.86 ± 0.98 d | 38.18 ± 0.66 b | 38.14 ± 1.5 a | 38.07 ± 0.68 b | 37.94 ± 1.24 a | 37.86 ± 1.26 a |
| P6 | 53.93 ± 0.32 ab | 51.19 ± 1.25 a | 47.07 ± 1.01 ab | 43.61 ± 1.31 bcd | 41.67 ± 0.89 ab | 39.49 ± 0.92 a | 39.45 ± 0.34 ab | 39.24 ± 1.61 a | 39.1 ± 1.64 a |
| P7 | 56.33 ± 0.8 ab | 53.67 ± 0.64 a | 49.91 ± 0.78 a | 49.8 ± 0.65 a | 41.54 ± 1.37 ab | 39.62 ± 1.87 a | 39.57 ± 1.12 ab | 39.4 ± 1.1 a | 39.29 ± 1.07 a |
| P8 | 56.96 ± 0.22 a | 54.28 ± 0.78 a | 49.18 ± 0.54 a | 44.2 ± 0.63 bc | 42.83 ± 0.41 a | 41.94 ± 0.54 a | 41.9 ± 0.37 a | 39.78 ± 0.89 a | 39.55 ± 0.74 a |
| F.test | 31.57 | 41.40 | 4.17 | 10.83 | 3.41 | 1.01 | 4.66 | 1.65 | 1.62 |
| p.val | 0.000 | 0.000 | 0.004 | 0.000 | 0.012 | 0.441 | 0.002 | 0.170 | 0.180 |
Publisher’s Note: MDPI stays neutral with regard to jurisdictional claims in published maps and institutional affiliations. |
© 2021 by the authors. Licensee MDPI, Basel, Switzerland. This article is an open access article distributed under the terms and conditions of the Creative Commons Attribution (CC BY) license (https://creativecommons.org/licenses/by/4.0/).
Share and Cite
Hegyi, A.; Grebenişan, E.; Lăzărescu, A.-V.; Stoian, V.; Szilagyi, H. Influence of TiO2 Nanoparticles on the Resistance of Cementitious Composite Materials to the Action of Fungal Species. Materials 2021, 14, 4442. https://doi.org/10.3390/ma14164442
Hegyi A, Grebenişan E, Lăzărescu A-V, Stoian V, Szilagyi H. Influence of TiO2 Nanoparticles on the Resistance of Cementitious Composite Materials to the Action of Fungal Species. Materials. 2021; 14(16):4442. https://doi.org/10.3390/ma14164442
Chicago/Turabian StyleHegyi, Andreea, Elvira Grebenişan, Adrian-Victor Lăzărescu, Vlad Stoian, and Henriette Szilagyi. 2021. "Influence of TiO2 Nanoparticles on the Resistance of Cementitious Composite Materials to the Action of Fungal Species" Materials 14, no. 16: 4442. https://doi.org/10.3390/ma14164442
APA StyleHegyi, A., Grebenişan, E., Lăzărescu, A.-V., Stoian, V., & Szilagyi, H. (2021). Influence of TiO2 Nanoparticles on the Resistance of Cementitious Composite Materials to the Action of Fungal Species. Materials, 14(16), 4442. https://doi.org/10.3390/ma14164442

